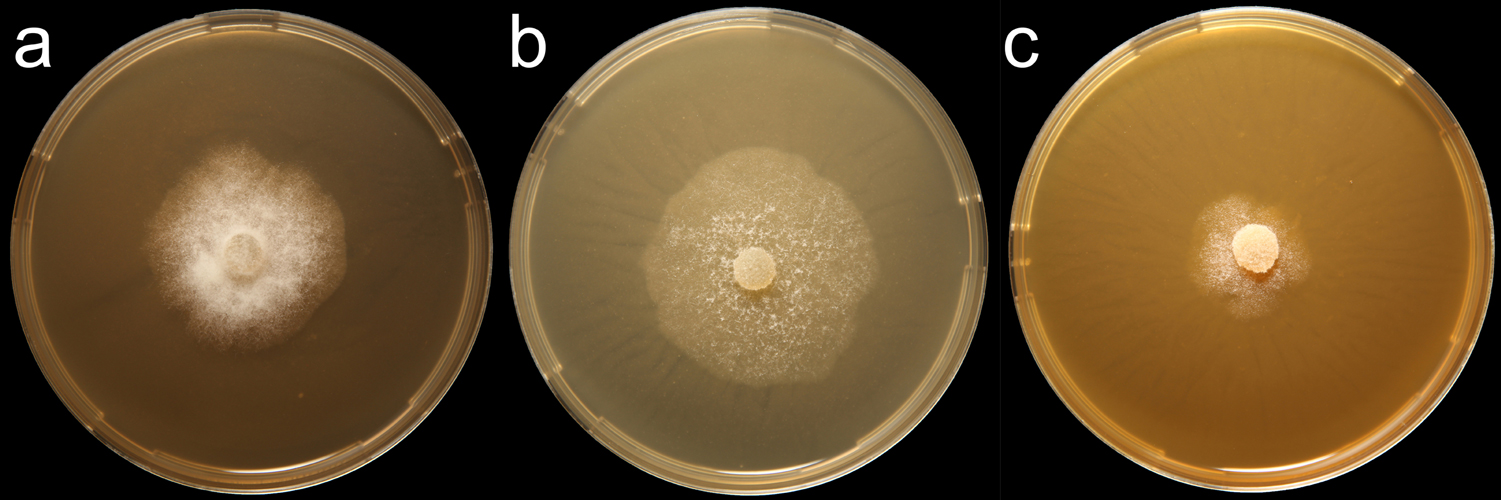

Phytophthora mexicana (in progress - Abad et al. 2023b)
|
Phytophthora spp. in subclade 2b: portion of the seven-loci ML phylogeny featuring the type cultures of 212 described species (by T. Bourret). Notice the position of P. mexicana selected specimen CBS 149405 = S&T BL 199. Gloria Abad, USDA S&T.
|
|
Phytophthora spp. in subclade 2b: Morphological Tabular key (PDF) and Tabular key legends (PDF) in IDphy2 KEY SECTION. Notice the data of P. mexicana selected specimen CBS 149405 = S&T BL 199. Gloria Abad, USDA S&T.
|
|
Phytophthora mexicana (CPHST BL 24) colonies of a selected specimen grown for 7 days on (a) V8® Agar, (b) potato dextrose agar, and (c) malt extract agar; photo by Krysta Jennings and Leandra Knight, USDA-APHIS-PPQ |
Name and publication
Phytophthora mexicana Hotson & Hartge (1923)
Hotson JW and Hartge L. 1923. A disease of tomato caused by Phytophthora mexicana sp. nov. Phytopathology 13: 520–531 (pg 520).
Nomenclature
Mycobank
Typification
from Hotson and Hartge (1923)
Type: MEXICO, collected form fruit of tomato (Lycopersicum esculentum Mill.) in the early summer 1917. The isolate was obtained from tomato shipped from Mexico into Seattle, Washington. Transfers were made to keep it alive until 1920 at which time the cultural study was begun.
Ex-type: LOST
Well-authenticated specimen selected by Gloria Abad:
Selected specimen #1: P0646 (WPC) = CPHST BL 24 A2 type from Solanum lycopersicum, ARGENTINA
Selected specimen in other collections
(SE) CBS 149405, S&T BL 199 (Abad), French Ph213, S972
Molecular identification
Voucher sequences for barcoding genes (ITS rDNA and COI) of the selected specimen (see Molecular protocols page)
Phytophthora mexicana isolate CPHST BL 24 (= P0646 WPC) = ITS rDNA MG865540, COI MH136933
Voucher sequences for Molecular Toolbox with seven genes (ITS, β-tub, COI, EF1α, HSP90, L10, and YPT1
(see Molecular protocols page) (In Progress)
Voucher sequences for Metabarcoding High-throughput Sequencing (HTS) Technologies [Molecular Operational Taxonomic Unit (MOTU)]
(see Molecular protocols page) (In Progress)
Sequences with multiple genes for selected specimen in other sources
- NCBI: Phytophthora mexicana CPHST BL 24
- NCBI: Phytophthora mexicana P0646
- EPPO-Q-bank: Phytophthora mexicana
- BOLDSYSTEMS: Phytophthora mexicana (barcoding COI & ITS)
Position in multigenic phylogeny with 7 genes (ITS, β-tub, COI, EF1α, HSP90, L10, and YPT1)
Clade 2b
Morphological identification
Colonies and cardinal temperatures:
Colonies on CMA, V8, and PDA xxxx. Minimum temperature for growth xx, optimum 24–27°C, and maximum 32°C.
Asexual phase
Sporangia papillate papillate:
pertaining to the production of a distinct papilla at the distal end of the sporangium (cf. nonpapillate and semipapillate)
to semipapillatesemipapillate:
pertaining to the production of shallow having papilla that are not well developed, shallow and less nipple-like than fully papillate structures
; persistentpersistent:
pertaining to sporangia that remain attached to the sporangiophore and do not separate or detach easily (cf. caducous)
; ovoidovoid:
egg-shaped, with the widest part at the base of the sporangium and the narrow part at the apex
, globoseglobose:
having a rounded form resembling that of a sphere
, irregular shape (16–33 x 16–77 µm), originated in simple and simple sympodial sporangiophores. Hyphal swellings absent. Chlamydospores occasionally produced and are globoseglobose:
having a rounded form resembling that of a sphere
, terminal, intercalaryintercalary:
positioned within a hypha (cf. terminal)
, and lateral.
Sexual phase
Homothallic. OogoniaOogonia:
the female gametangium in which the oospore forms after fertilization by the antheridium
terminal, smooth-walled (24–37 µm); antheridiaantheridia:
the male gametangium; a multinucleate, swollen hyphal tip affixed firmly to the wall of the female gametangium (the oogonium)
predominantly amphigynousamphigynous:
pertaining to the sexual stage in which the antheridium completely surrounds the stalk of the oogonium (cf. paragynous)
; oospores plerotic.
Specimen(s) evaluated
Phytophthora mexicana CPHST BL 24, duplicate of P0646 (World Oomycetes/Phytophthora Collection)
Hosts and distribution
Distribution: North America (Mexico, type); possibly introduced from the Netherlands (Erwin & Ribeiro 1996)
Substrate: fruit
Disease note: fruit rot; also black wilt and damping off
Host: Solanum lycopersicum (Solanaceae)
Retrieved January 31, 2018 from U.S. National Fungus Collections Nomenclature Database.
Additional references and links
- SMML USDA-ARS: Phytophthora mexicana
- EPPO Global Database: Phytophthora mexicana
- Forest Phytophthoras of the world: Phytophthora mexicana
- CABI Digital Library: Phytophthora mexicana
- Encyclopedia of Life (EOL): Phytophthora mexicana
- Index Fungorum (IF): Phytophthora mexicana
- Google All Phytophthora mexicana
- Google Images Phytophthora mexicana
- Google Scholar Phytophthora mexicana
Fact sheet author
Z. Gloria Abad, Ph.D., USDA-APHIS-PPQ-S&T Plant Pathogen Confirmatory Diagnostics Laboratory (PPCDL), United States of America.